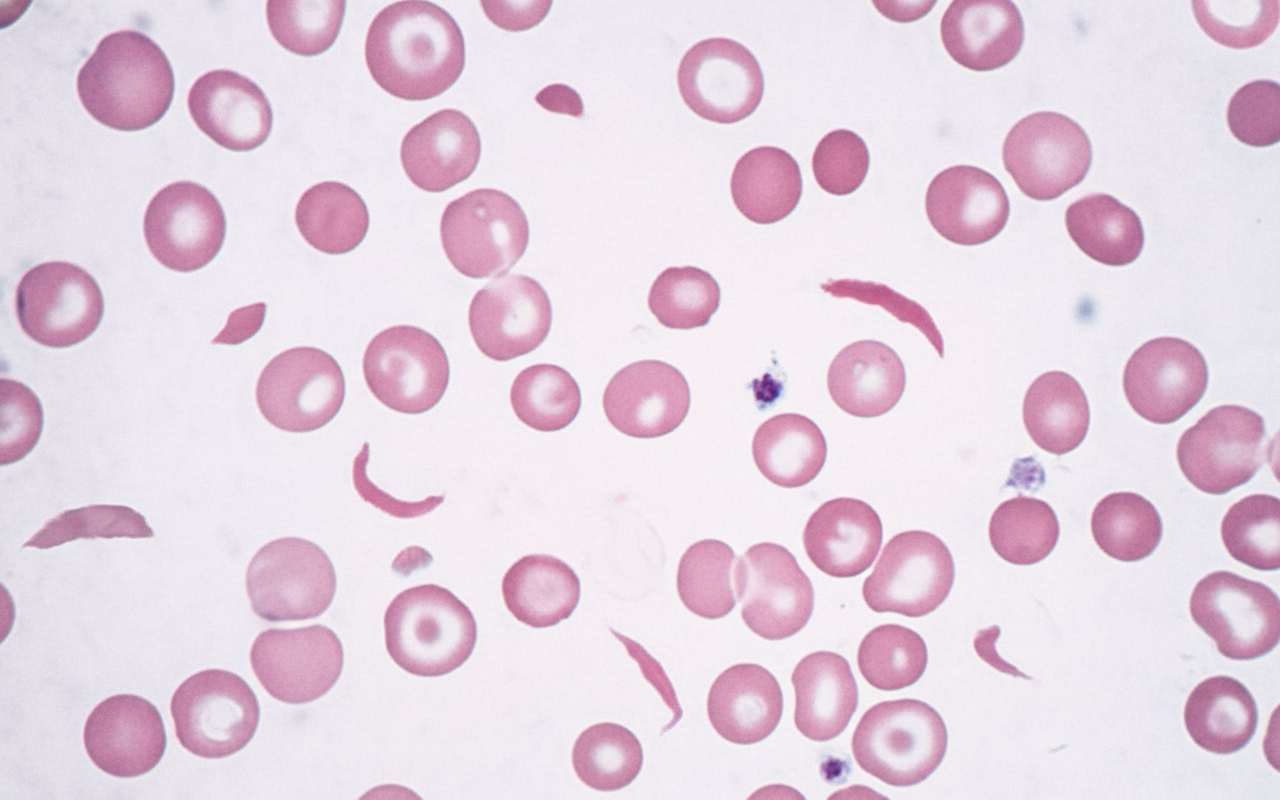
Image for question 92

A blood smear is best visualized at which pH?
Which of the following is not associated with the disorder characterized by findings on a peripheral blood smear?
Estimation of the degradation products of the cross-linked fibrin fibers in DIC can best, specifically, and accurately be done by which of the following tests?
Which of the following statements regarding megaloblastic anemia is true?
Stored blood, which has been preserved in a blood bank, is deficient in which of the following coagulation factors?
A 62-year-old man develops itchy, scaling, and non-scaling patches and plaques over his chest and back. The rest of the examination is normal, except for lymphadenopathy. Blood film and skin biopsy histology both reveal unusually large monocytoid cells. Which of the following is the most likely diagnosis?
Which of the following conditions is LEAST likely to be accompanied by lymphocytosis in the peripheral blood?
Which of the following subtypes of Acute Myeloid Leukemia (AML) is characterized by gum hyperplasia, bleeding, and visceral infiltration?
A localized presentation of Non-Hodgkin Lymphoma (NHL) is typically associated with which histological subtype?
A 72-year-old female presents with complaints of generalized lymphadenopathy and a total WBC count of 80,000. Flow cytometry revealed CD19+, CD20+, CD5+, CD23-. Cyclin D1 is positive. Which of the following genetic abnormalities is expected in this condition?
Explanation: The visualization of a peripheral blood smear depends on the **Romanowsky group of stains** (e.g., Leishman, Wright, or Giemsa stains). These stains are "polychromatic," consisting of a mixture of Methylene Blue (basic) and Eosin (acidic) dyes [1]. **Why 6.8 is the Correct Answer:** The optimal pH for staining blood films is **6.8**. At this specific pH, the ionization of the dye components is perfectly balanced, allowing for the characteristic "differential" staining: * **Acidic structures** (like DNA in the nucleus) take up the basic Methylene Blue, appearing purple/blue. * **Basic structures** (like Hemoglobin) take up the acidic Eosin, appearing pink/orange [2]. A pH of 6.8 ensures that the red blood cells (RBCs) appear buff-pink and the granules of white blood cells (WBCs) are clearly demarcated. **Analysis of Incorrect Options:** * **7.0 and 7.2 (Alkaline):** If the pH is too basic, the stain becomes "over-blue." RBCs appear gray or greenish, and eosinophilic granules (like those in eosinophils) may not stain properly, making identification difficult. * **6.6 (Acidic):** If the pH is too acidic, the stain becomes "over-pink." The nuclei of WBCs will appear pale or faint, and the overall contrast between the nucleus and cytoplasm is lost. **High-Yield Clinical Pearls for NEET-PG:** * **Buffer used:** Sorensen’s phosphate buffer is typically used to maintain the pH at 6.8. * **Fixative:** Methanol is the most common fixative used in blood film preparation to prevent the lysis of RBCs by the water in the stain. * **Common Error:** If a smear is too thick or washed with tap water (which is often alkaline), it may appear excessively blue, mimicking a high pH error. **References:** [1] Cross SS. Underwood's Pathology: A Clinical Approach. 6th ed. Common Clinical Problems From Blood And Bone Marrow Disease, pp. 578-579. [2] Cross SS. Underwood's Pathology: A Clinical Approach. 6th ed. Common Clinical Problems From Blood And Bone Marrow Disease, pp. 577-578.
Explanation: ***Predisposition to malaria*** - Sickle cell disease/trait actually provides **protection against malaria**, not predisposition, due to the **hostile environment** for Plasmodium parasites in sickled red blood cells. - This protective effect is an evolutionary advantage in **malaria-endemic regions**, explaining the high prevalence of sickle cell trait in these areas. *Hand-foot syndrome* - Also known as **dactylitis**, this is a common complication of sickle cell disease caused by **vaso-occlusive crises** in small bones. - Results in painful swelling of hands and feet, particularly common in **infants and young children** with sickle cell disease. *Acute chest syndrome* - A serious complication of sickle cell disease involving **pulmonary vaso-occlusion**, infection, or fat embolism. - Presents with chest pain, fever, and **pulmonary infiltrates** on chest X-ray, requiring immediate medical attention. *Predisposition to Salmonella osteomyelitis* - Occurs due to **functional asplenia** from repeated splenic infarctions in sickle cell disease patients. - **Salmonella** species have particular tropism for infarcted bone tissue, making osteomyelitis more common than **Staphylococcus aureus** in these patients.
Explanation: ### Explanation **Correct Answer: B. D-dimer assay** **Why it is correct:** Disseminated Intravascular Coagulation (DIC) is characterized by widespread activation of the coagulation cascade, leading to the formation of **cross-linked fibrin** clots [3]. To counteract this, the fibrinolytic system is activated, and plasmin begins to break down these stable clots [2]. **D-dimers** are specific degradation products released only when **cross-linked fibrin** (stabilized by Factor XIIIa) is cleaved by plasmin [1]. Therefore, a positive D-dimer test specifically indicates that both thrombin (to form the clot) and plasmin (to break it down) have been active, making it the most specific and accurate marker for DIC. **Why other options are incorrect:** * **A. Fibrinopeptide assay:** These are released when fibrinogen is converted to fibrin monomer by thrombin [3]. They indicate thrombin activity but do not specifically reflect the breakdown of a stable, cross-linked clot. * **C. Euglobulin lysis test:** This is an older test used to measure overall systemic fibrinolytic activity. It is not specific for the degradation of cross-linked fibrin and is rarely used in modern clinical practice for DIC. * **D. Coombs test:** This is used to detect antibodies on the surface of RBCs (Direct) or in the serum (Indirect) in cases of autoimmune hemolytic anemia. It has no role in assessing the coagulation cascade or fibrinolysis. **Clinical Pearls for NEET-PG:** * **D-dimer vs. FDP:** Fibrin Degradation Products (FDPs) can result from the breakdown of both fibrinogen and fibrin. **D-dimer is more specific** because it only arises from cross-linked fibrin [1]. * **DIC Triad:** Low platelets, prolonged PT/aPTT, and elevated D-dimer. * **Schistocytes:** Always look for fragmented RBCs (schistocytes) on a peripheral smear in DIC, indicating microangiopathic hemolytic anemia (MAHA). **References:** [1] Cross SS. Underwood's Pathology: A Clinical Approach. 6th ed. (Basic Pathology) introduces the student to key general principles of pathology, both as a medical science and as a clinical activity with a vital role in patient care. Part 2 (Disease Mechanisms) provides fundamental knowledge about the cellular and molecular processes involved in diseases, providing the rationale for their treatment. Part 3 (Systematic Pathology) deals in detail with specific diseases, with emphasis on the clinically important aspects., pp. 151-152. [2] Kumar V, Abbas AK, et al.. Robbins and Cotran Pathologic Basis of Disease. 9th ed. Hemodynamic Disorders, Thromboembolic Disease, and Shock, pp. 130-132. [3] Kumar V, Abbas AK, et al.. Robbins and Cotran Pathologic Basis of Disease. 9th ed. Hemodynamic Disorders, Thromboembolic Disease, and Shock, p. 130.
Explanation: **Explanation:** Megaloblastic anemia is characterized by impaired DNA synthesis, most commonly due to Vitamin B12 or Folate deficiency [1]. This leads to a maturation lag between the nucleus and the cytoplasm (nuclear-cytoplasmic asynchrony) [2]. **Why Option C is correct:** In megaloblastic anemia, there is significant **ineffective erythropoiesis**. The abnormal, fragile megaloblastic precursors undergo premature destruction within the bone marrow before they can enter the circulation (intramedullary hemolysis). This destruction releases high amounts of intracellular enzymes, leading to a **marked increase in Serum LDH** (often >1000 IU/L) and indirect bilirubin. **Analysis of Incorrect Options:** * **Option A:** While megaloblastic precursors *are* present in the bone marrow [1], this statement is technically a defining feature rather than the "most true" clinical finding in the context of typical MCQ patterns where biochemical markers are prioritized. However, in many standard texts, this is a characteristic finding. *Note: In competitive exams, if multiple options seem true, look for the most specific metabolic consequence.* * **Option B:** While MCV is indeed increased (>100 fL), this is a feature of **Macrocytic Anemia**. Not all macrocytic anemias are megaloblastic (e.g., hypothyroidism, liver disease). * **Option D:** Megaloblastic anemia typically causes **Pancytopenia** (anemia, leucopenia, and thrombocytopenia) due to the global defect in DNA synthesis affecting all cell lines. Therefore, **thrombocytopenia** occurs, not thrombocytosis. **High-Yield Clinical Pearls for NEET-PG:** * **Peripheral Smear:** Look for **Hypersegmented Neutrophils** [1] (earliest sign) and Macro-ovalocytes [2]. * **Bone Marrow:** Shows hypercellularity with "Checkered-board" chromatin pattern in erythroid precursors [2]. * **Neurological Symptoms:** Subacute Combined Degeneration (SCD) of the spinal cord is seen in **B12 deficiency only**, not in folate deficiency. * **Schilling Test:** Historically used to differentiate causes of B12 malabsorption (though now largely replaced by antibody testing). **References:** [1] Kumar V, Abbas AK, et al.. Robbins and Cotran Pathologic Basis of Disease. 9th ed. Red Blood Cell and Bleeding Disorders, pp. 654-655. [2] Cross SS. Underwood's Pathology: A Clinical Approach. 6th ed. Common Clinical Problems From Blood And Bone Marrow Disease, pp. 593-594.
Explanation: **Explanation:** The correct answer is **V and VIII** because these are known as **labile coagulation factors**. In blood bank storage (typically at 1–6°C in CPDA-1), the activity of most coagulation factors remains relatively stable. However, Factors V and VIII are highly sensitive to temperature and storage time. Their activity begins to decline significantly within 24–48 hours of collection. By the time a unit of whole blood reaches its expiration (35–42 days), these factors are virtually absent. This is why patients requiring these specific factors (e.g., in Hemophilia A or massive transfusion) require **Fresh Frozen Plasma (FFP)** or **Cryoprecipitate**, where these factors are preserved by rapid freezing. **Analysis of Incorrect Options:** * **Option A & B (II and VII):** Factor II (Prothrombin) and Factor VII are **stable factors** [1]. They maintain adequate activity levels throughout the shelf-life of stored blood. * **Option D (IX and X):** These are also stable factors. Along with Factors II and VII, they are Vitamin K-dependent and do not degrade significantly during standard refrigerated storage [2]. **NEET-PG High-Yield Pearls:** 1. **Massive Transfusion Complication:** Transfusing large volumes of stored blood (which lacks V and VIII) can lead to **dilutional coagulopathy**. 2. **Storage Lesion:** This term refers to the biochemical and morphological changes in stored blood, including decreased 2,3-DPG (shifting the oxygen dissociation curve to the left), decreased pH, and increased potassium. 3. **Factor VIII Source:** Cryoprecipitate is the richest source of Factor VIII, Fibrinogen, and von Willebrand Factor (vWF). **References:** [1] Cross SS. Underwood's Pathology: A Clinical Approach. 6th ed. Common Clinical Problems From Blood And Bone Marrow Disease, pp. 582-583. [2] Cross SS. Underwood's Pathology: A Clinical Approach. 6th ed. Common Clinical Problems From Blood And Bone Marrow Disease, pp. 624-625.
Explanation: **Explanation:** The clinical presentation of itchy, scaling patches and plaques in an elderly patient, combined with lymphadenopathy and the presence of "unusually large monocytoid cells" (Cerebriform nuclei), is classic for **Mycosis Fungoides (MF)**, the most common form of **Primary Cutaneous T-cell Lymphoma (CTCL)** [1]. 1. **Why Option C is correct:** MF typically progresses through three stages: patch, plaque, and tumor [1][2]. The "monocytoid cells" described are **Sézary cells**—malignant CD4+ T-helper cells characterized by hyperconvoluted, **cerebriform nuclei** [3]. When these cells involve the skin, they form Pautrier’s microabscesses [1]. If they circulate in the peripheral blood (as suggested by the blood film), the condition is termed **Sézary Syndrome**, the leukemic phase of CTCL [3]. 2. **Why other options are incorrect:** * **Leukemia (A):** While Sézary syndrome is leukemic, "Leukemia" is too broad. Primary bone marrow leukemias (like AML/CLL) typically present with cytopenias and do not primarily manifest as chronic scaling skin plaques. * **Visceral B-cell lymphoma (B):** These usually present with bulky lymphadenopathy or organomegaly. While skin involvement can occur (secondary), the specific "monocytoid/cerebriform" morphology is a hallmark of T-cell lineage, not B-cell. * **Viral infection (D):** EBV typically causes Infectious Mononucleosis, characterized by "atypical lymphocytes" (Downey cells) which are reactive CD8+ T-cells, not the large, cerebriform malignant cells seen here. **High-Yield Pearls for NEET-PG:** * **Pathognomonic Feature:** **Pautrier’s microabscesses** (clusters of Sézary cells in the epidermis) [1]. * **Immunophenotype:** Usually **CD3+ and CD4+** (T-helper cells) [2]. * **Sézary Syndrome Triad:** Erythroderma (exfoliative dermatitis), lymphadenopathy, and circulating cerebriform T-cells (>1000/mm³). * **Clinical Hint:** Any chronic "dermatitis" or "psoriasis" that is refractory to standard treatment in an elderly patient should raise suspicion for CTCL [2]. **References:** [1] Cross SS. Underwood's Pathology: A Clinical Approach. 6th ed. Common Clinical Problems From Diseases Of The Urinary And Male Genital Tracts, pp. 564-565. [2] Kumar V, Abbas AK, et al.. Robbins and Cotran Pathologic Basis of Disease. 9th ed. The Skin, p. 1162. [3] Kumar V, Abbas AK, et al.. Robbins and Cotran Pathologic Basis of Disease. 9th ed. Diseases of White Blood Cells, Lymph Nodes, Spleen, and Thymus, pp. 613-614.
Explanation: **Explanation:** The core concept in hematopathology is that different pathogens trigger specific immune responses. **Bacterial infections** (Option C) typically induce a **neutrophilic leukocytosis** (left shift) due to the release of pyogenic factors that stimulate the bone marrow to release neutrophils [1],[2]. Lymphocytosis is not a characteristic feature of acute bacterial infections, making it the least likely cause among the choices. **Analysis of Options:** * **Viral Infections (Option A):** These are the most common cause of lymphocytosis [1]. Viruses like EBV (Infectious Mononucleosis), CMV, and Hepatitis trigger a T-cell mediated immune response, often resulting in "atypical lymphocytes" (Downey cells) [3]. * **Fungal Infections (Option B):** Chronic fungal infections (e.g., Histoplasmosis, Coccidioidomycosis) often present with a granulomatous inflammatory response, which is frequently accompanied by a relative or absolute lymphocytosis and monocytosis [4]. * **Protozoal Infections (Option D):** Certain protozoal infections, most notably **Toxoplasmosis**, are well-known to cause a clinical picture mimicking viral mononucleosis, including significant peripheral lymphocytosis [5]. **High-Yield NEET-PG Pearls:** 1. **Exceptions to the Rule:** While most bacteria cause neutrophilia, **Bordetella pertussis** (Whooping cough) is a classic exception that causes profound **lymphocytosis** due to a toxin that prevents lymphocytes from entering the lymph nodes [1]. 2. **Atypical Lymphocytes:** Large, reactive CD8+ T-cells with abundant cytoplasm "hugging" adjacent RBCs; most commonly seen in EBV [3]. 3. **Absolute Lymphocytosis:** Defined in adults as a lymphocyte count >4,000/µL. **References:** [1] Cross SS. Underwood's Pathology: A Clinical Approach. 6th ed. (Basic Pathology) introduces the student to key general principles of pathology, both as a medical science and as a clinical activity with a vital role in patient care. Part 2 (Disease Mechanisms) provides fundamental knowledge about the cellular and molecular processes involved in diseases, providing the rationale for their treatment. Part 3 (Systematic Pathology) deals in detail with specific diseases, with emphasis on the clinically important aspects., pp. 195-196. [2] Kumar V, Abbas AK, et al.. Robbins and Cotran Pathologic Basis of Disease. 9th ed. Diseases of White Blood Cells, Lymph Nodes, Spleen, and Thymus, p. 592. [3] Kumar V, Abbas AK, et al.. Robbins and Cotran Pathologic Basis of Disease. 9th ed. Infectious Diseases, pp. 369-370. [4] Kumar V, Abbas AK, et al.. Robbins and Cotran Pathologic Basis of Disease. 9th ed. Infectious Diseases, p. 360. [5] Kumar V, Abbas AK, et al.. Robbins and Cotran Pathologic Basis of Disease. 9th ed. The Central Nervous System, pp. 1274-1275.
Explanation: **Explanation:** The correct answer is **Monocytic (AML-M4/M5)**. **1. Why Monocytic is Correct:** Acute Monocytic Leukemia (FAB classification M5) and Acute Myelomonocytic Leukemia (M4) are uniquely characterized by the infiltration of malignant monocytes into extra-medullary tissues. Monocytes have a high propensity for tissue migration. This leads to classic clinical signs: * **Gum Hyperplasia:** Infiltration of the gingiva by leukemic cells [3]. * **Visceral Infiltration:** Involvement of the liver, spleen, and skin (Leukemia cutis) [3]. * **Bleeding:** Often associated with Disseminated Intravascular Coagulation (DIC), though less frequent than in M3 [2], [3]. **2. Why Other Options are Incorrect:** * **Promyelocytic (M3):** Characterized by the t(15;17) translocation and Auer rods [1], [2]. While it is the subtype most strongly associated with **DIC and life-threatening bleeding** [2], [3], it does not typically cause gum hyperplasia. * **Megakaryocytic (M7):** Associated with Down Syndrome (in children <5 years) and often presents with extensive bone marrow fibrosis (myelofibrosis). * **Erythrocytic (M6):** Characterized by the proliferation of erythroid precursors; it does not show a predilection for gingival or visceral infiltration. **3. NEET-PG High-Yield Pearls:** * **M4/M5:** Look for "Gum Hyperplasia" and "Nonspecific Esterase (NSE) Positivity" (inhibited by sodium fluoride). * **M3:** Look for "Auer Rods," "Faggot Cells," and "ATRA treatment" [1], [2]. * **M7:** Most common AML in Down Syndrome patients under age 5. * **M2:** Associated with t(8;21) and has a relatively good prognosis [2]. **References:** [1] Kumar V, Abbas AK, et al.. Robbins and Cotran Pathologic Basis of Disease. 9th ed. Diseases of White Blood Cells, Lymph Nodes, Spleen, and Thymus, pp. 621-622. [2] Kumar V, Abbas AK, et al.. Robbins and Cotran Pathologic Basis of Disease. 9th ed. Diseases of White Blood Cells, Lymph Nodes, Spleen, and Thymus, p. 620. [3] Cross SS. Underwood's Pathology: A Clinical Approach. 6th ed. Common Clinical Problems From Blood And Bone Marrow Disease, pp. 608-610.
Explanation: **Explanation:** The clinical presentation of Non-Hodgkin Lymphoma (NHL) is heavily influenced by its histological growth pattern and grade. **Why "Nodular well differentiated" is correct:** In the Rappaport classification (historically significant for exams), **Nodular (Follicular)** lymphomas are generally low-grade and characterized by a slow, indolent clinical course [1]. Specifically, "Nodular well differentiated" lymphocytic lymphoma tends to remain localized to specific lymph node groups for longer periods before systemic dissemination. These cells mimic the organized structure of germinal centers, leading to a more contained growth pattern compared to their diffuse counterparts [2]. **Analysis of Incorrect Options:** * **Diffuse:** Diffuse lymphomas (like Diffuse Large B-Cell Lymphoma) lack a follicular architecture. They are aggressive, high-grade malignancies that infiltrate the node rapidly and often present with early systemic involvement, bulky disease, and "B" symptoms [3]. * **Nodular poorly differentiated:** While still nodular, "poorly differentiated" implies a higher grade of cytological atypia (more lymphoblasts/large cells). These are more biologically active than well-differentiated types and have a higher propensity for early spread. **High-Yield Clinical Pearls for NEET-PG:** * **Growth Pattern Rule:** Nodular/Follicular patterns generally carry a better prognosis but are often harder to cure completely; Diffuse patterns are more aggressive but often more responsive to chemotherapy. * **Most Common NHL:** Diffuse Large B-Cell Lymphoma (DLBCL) is the most common subtype worldwide. * **Cytogenetics:** Follicular lymphoma is classically associated with the **t(14;18)** translocation, leading to the overexpression of the **BCL-2** anti-apoptotic protein [1]. * **Staging:** Unlike Hodgkin Lymphoma, which spreads contiguously, NHL is characterized by non-contiguous spread and frequent extranodal involvement. **References:** [1] Cross SS. Underwood's Pathology: A Clinical Approach. 6th ed. Common Clinical Problems From Diseases Of The Urinary And Male Genital Tracts, pp. 561-562. [2] Kumar V, Abbas AK, et al.. Robbins and Cotran Pathologic Basis of Disease. 9th ed. Diseases of White Blood Cells, Lymph Nodes, Spleen, and Thymus, pp. 602-604. [3] Cross SS. Underwood's Pathology: A Clinical Approach. 6th ed. Common Clinical Problems From Diseases Of The Urinary And Male Genital Tracts, pp. 563-564.
Explanation: ### Explanation The clinical presentation and immunophenotype point toward a diagnosis of **Mantle Cell Lymphoma (MCL)**. **1. Why t(11;14) is correct:** The key diagnostic markers in this case are **CD5+**, **CD23-**, and **Cyclin D1 positivity** [1]. While both Chronic Lymphocytic Leukemia (CLL) and MCL are CD5+ B-cell neoplasms, MCL is characteristically CD23 negative and expresses Cyclin D1 [1]. The genetic hallmark of MCL is **t(11;14)(q13;q32)**. This translocation involves the *CCND1* gene (Cyclin D1) on chromosome 11 and the *IGH* gene (Immunoglobulin Heavy chain) on chromosome 14. This leads to the overexpression of Cyclin D1, which promotes cell cycle progression from G1 to S phase. **2. Why the other options are incorrect:** * **t(8;21):** Associated with **Acute Myeloid Leukemia (AML-M2)**; it involves the *RUNX1-RUNX1T1* fusion. * **13q deletion:** The most common cytogenetic abnormality in **CLL/SLL**. CLL is typically CD5+ but, unlike this case, it is **CD23+** and Cyclin D1 negative [1]. * **t(11;18):** Associated with **MALT lymphoma** (Marginal Zone Lymphoma); it involves the *BIRC3-MALT1* fusion. **3. High-Yield Clinical Pearls for NEET-PG:** * **Mantle Cell Lymphoma:** Typically presents in elderly males with lymphadenopathy and often involves the GI tract (Lymphomatous polyposis). * **Immunophenotype Triad:** CD5+, CD23 negative, and FMC7+. * **Cyclin D1:** Overexpression is the "gold standard" for diagnosis; if Cyclin D1 is negative, **SOX11** is used as a highly specific alternative marker [1]. * **CLL vs. MCL:** Always check CD23. **CLL = CD23+**; **MCL = CD23-** [1]. **References:** [1] Kumar V, Abbas AK, et al.. Robbins and Cotran Pathologic Basis of Disease. 9th ed. Diseases of White Blood Cells, Lymph Nodes, Spleen, and Thymus, pp. 610-612.
Anemias: Classification and Approach
Practice Questions
Hemolytic Anemias
Practice Questions
Myeloproliferative Neoplasms
Practice Questions
Myelodysplastic Syndromes
Practice Questions
Acute Leukemias
Practice Questions
Chronic Leukemias
Practice Questions
Lymphomas and Lymphoid Neoplasms
Practice Questions
Plasma Cell Disorders
Practice Questions
Bleeding Disorders
Practice Questions
Thrombotic Disorders
Practice Questions
Get full access to all questions, explanations, and performance tracking.
Start For Free